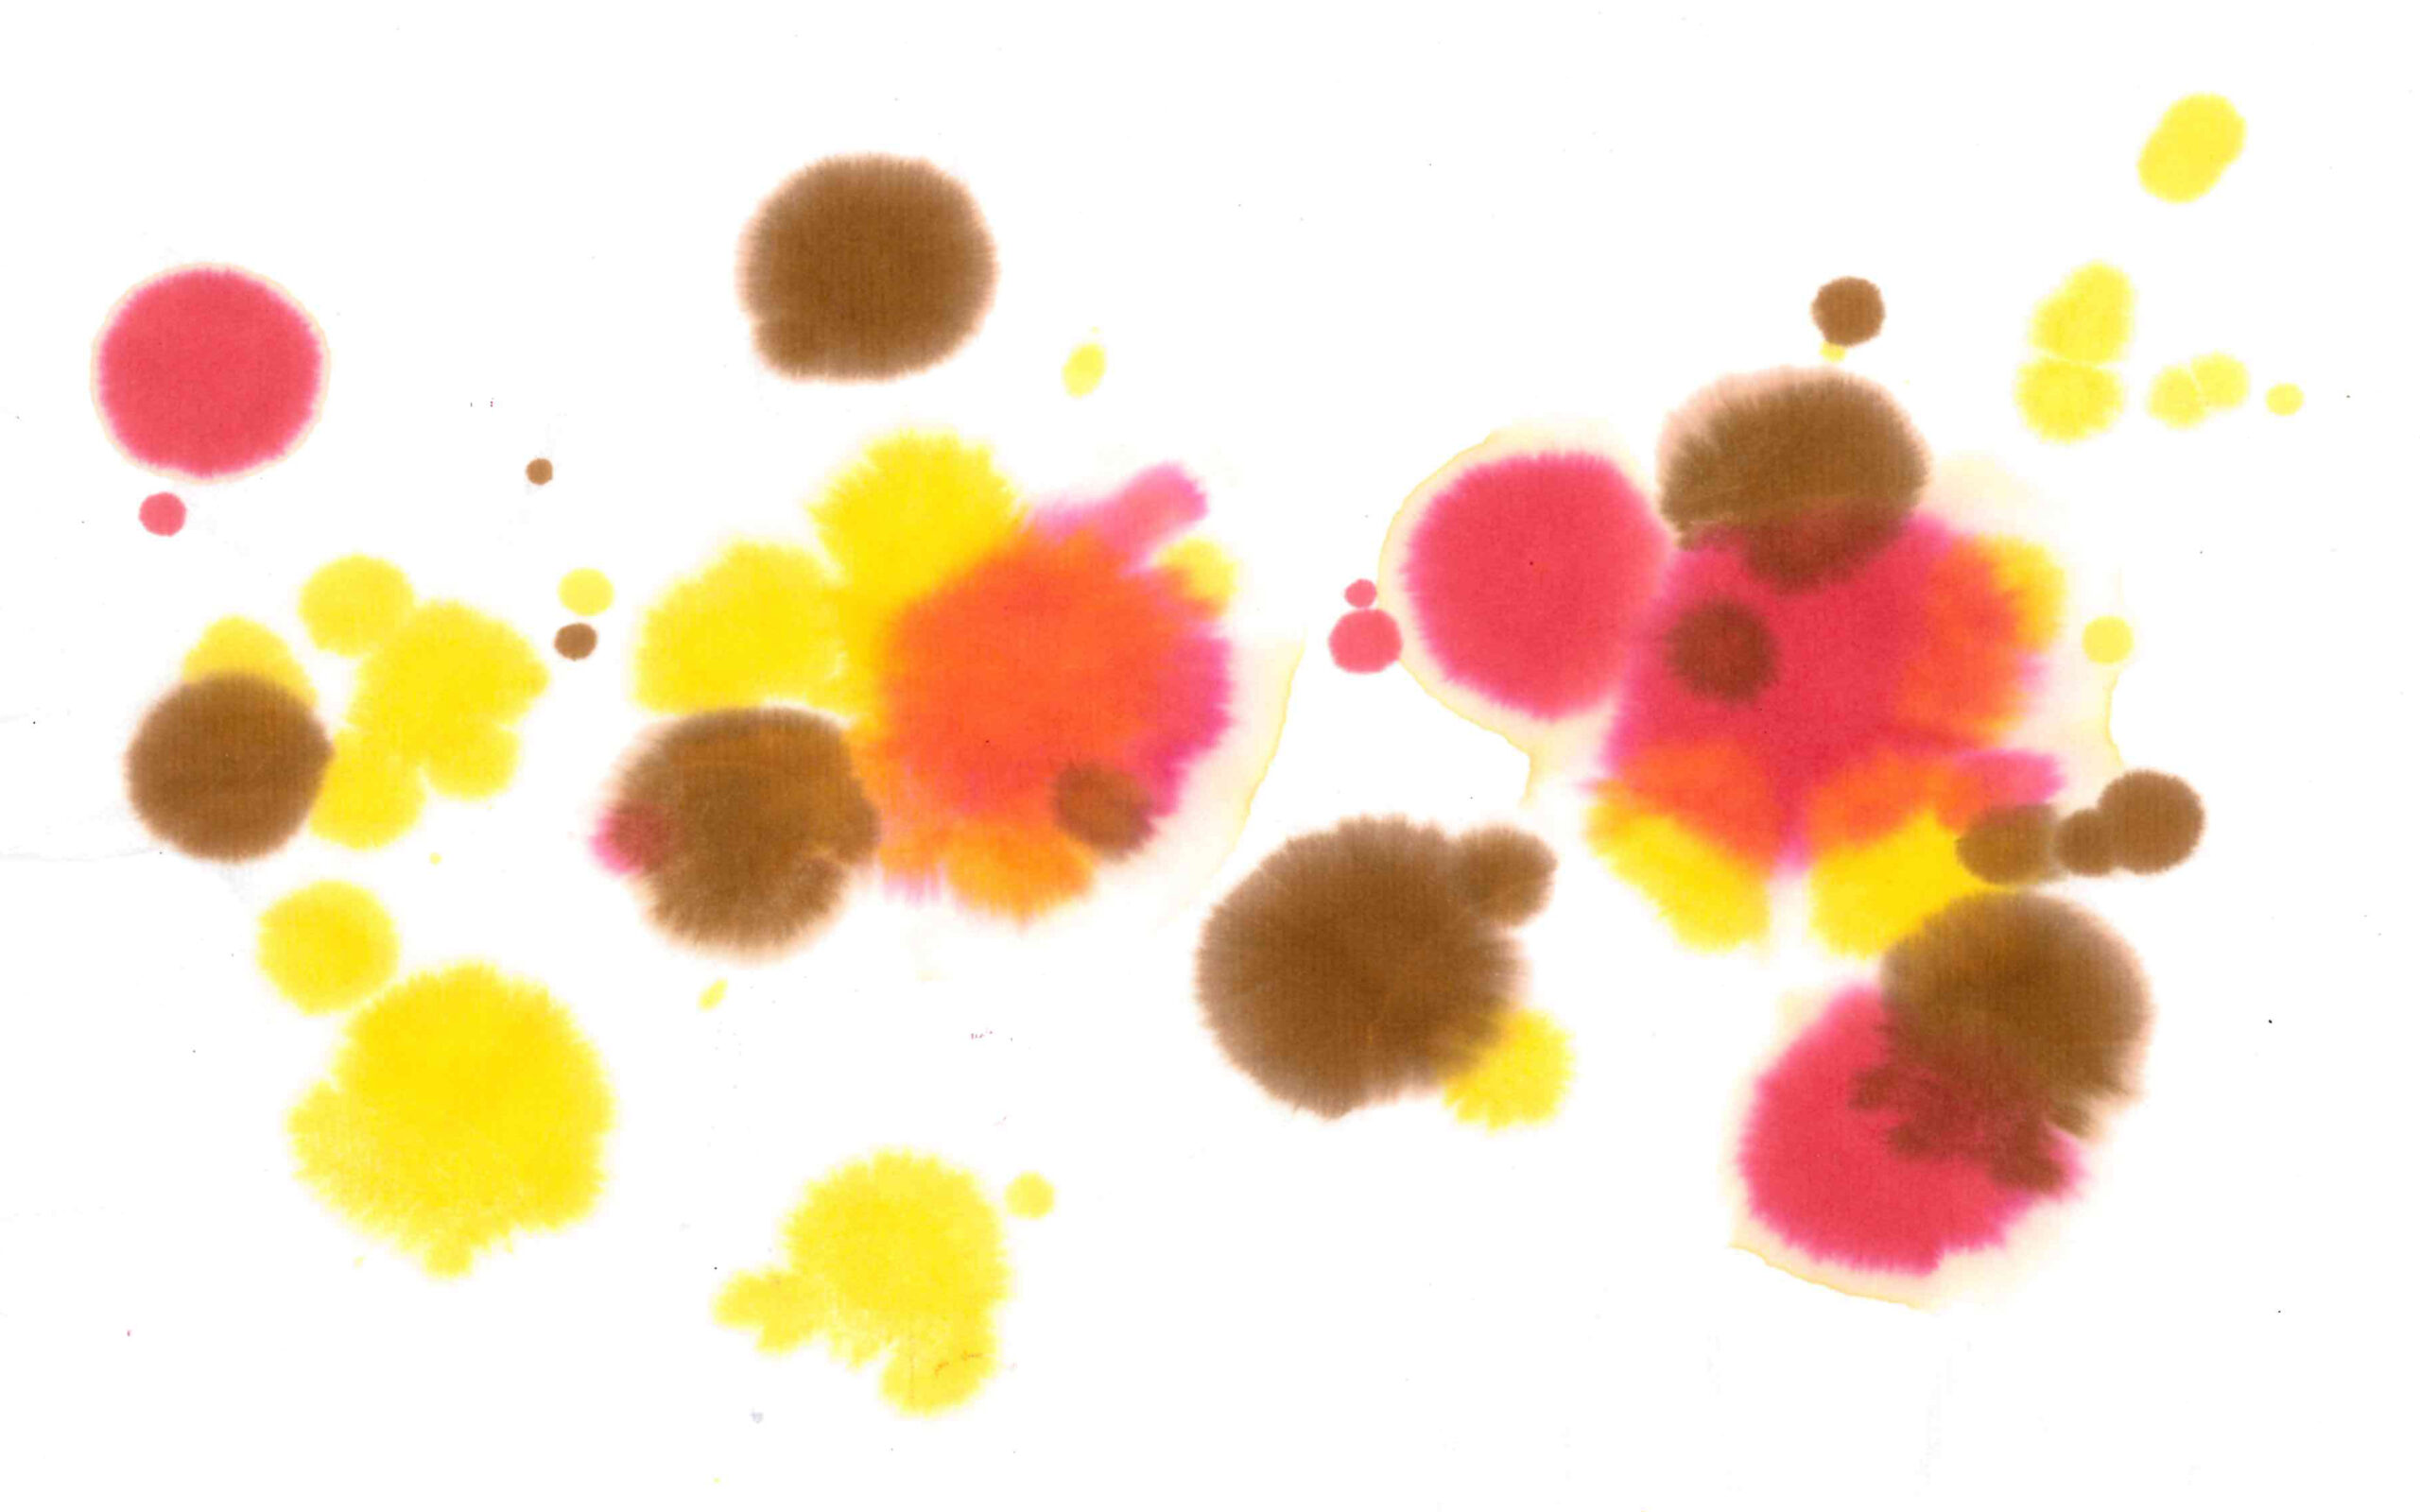
2168510

みやこ染 和紙ぞめカラー 500ml 黄
3,850円(税込)
在庫:在庫有り
折り染め・筆描きなど和紙専用の液体染料。お子様も手軽に楽しめる
和紙の質感を損なわない粒子の細かい、和紙専用の染料です。
折り紙のように和紙を折って染める”折り染め”をはじめ、低年齢から 大人まで、不思議と懐かしい、染色を楽しめます。
原液そのままでも、お水で薄めてもご利用いただけます。
欧州の玩具安全規格(EN71 Part 3 2013)に適合しております。
折り紙のように和紙を折って染める”折り染め”をはじめ、低年齢から 大人まで、不思議と懐かしい、染色を楽しめます。
原液そのままでも、お水で薄めてもご利用いただけます。
欧州の玩具安全規格(EN71 Part 3 2013)に適合しております。
アイテム詳細
- 染料・顔料
- 染料
- 色数
- 8色
- 容量
- 500ml
- タイプ
- 液体